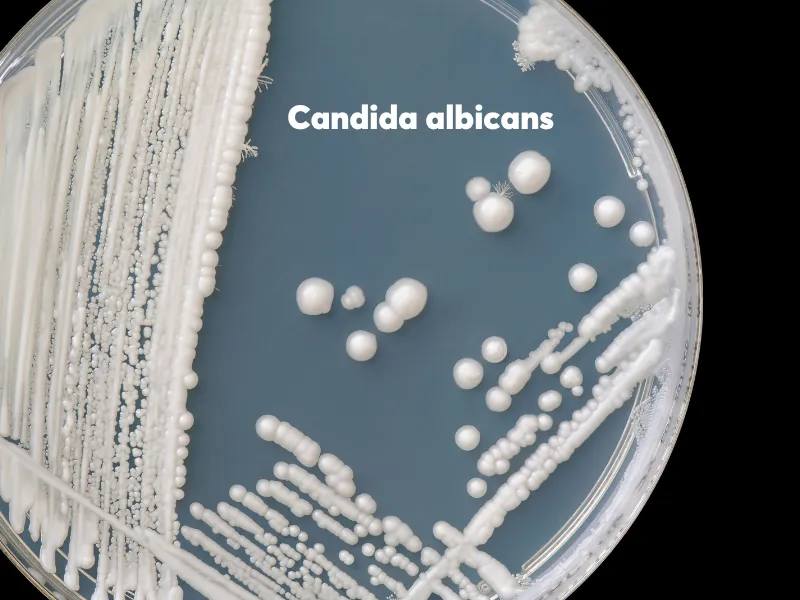
Nguyên nhân nấm da ở trẻ sơ sinh

Nấm da ở trẻ sơ sinh là tình trạng thường gặp nhưng dễ bị cha mẹ nhầm lẫn với hăm tã và chủ quan bỏ qua. Tuy nhiên, nếu không phát hiện sớm và xử lý đúng cách, nấm da có thể lan rộng, gây ngứa rát, khó chịu và ảnh hưởng đến sự phát triển của trẻ, Bài viết dưới đây của Daibaccare sẽ giúp cha mẹ hiểu rõ dấu hiệu nhận biết, nguyên nhân cũng như cách phòng ngừa nấm da hiệu quả cho làn da trẻ luôn mịn màng khỏe mạnh.
Nấm da ở trẻ sơ sinh là gì?
“Nấm da ở trẻ sơ sinh” là cách gọi thường dùng để chỉ tình trạng da nhiễm các loại vi nấm (thường là chủng men như Candida albicans hoặc nấm da thông thường) xảy ra trên làn da non nớt của trẻ nhỏ như mông, bẹn, cổ… và thường gặp nhất ở trẻ dưới 2 tuổi do hệ miễn dịch chưa toàn diện, dễ bị mầm bệnh tấn công.
Một số loại nấm chỉ gây ra kích ứng nhỏ cho trẻ, tuy nhiên, cũng có những chủng nấm khác xâm nhập sâu hơn và có thể gây ngứa, sưng, phồng rộp hoặc bong tróc, khó chịu cho trẻ. Và nếu không được phát hiện và xử lý kịp thời — đặc biệt đối với trẻ sinh thiếu tháng hoặc có thiếu cân — nấm da vẫn có thể tiến triển nặng hoặc tái phát.
Nguyên nhân nấm da ở trẻ sơ sinh
Nguyên nhân chính
Nguyên nhân chính dẫn đến tình trạng nấm da ở trẻ sơ sinh và trẻ nhỏ là do vi nấm (phổ biến nhất là chủng Candida albicans) phát triển mạnh trong môi trường ẩm ướt, bí bách như vùng tã lót, bẹn, kẽ ngón chân, ngón tay.
Theo các chuyên gia từ Cleveland Clinic: “Nấm men, đặc biệt là Candida albicans, có thể gây nấm da ở trẻ nếu sự cân bằng giữa nấm và vi khuẩn lành mạnh bị phá vỡ”.
Các yếu tố làm tăng nguy cơ nhiễm nấm
- Hệ miễn dịch chưa hoàn thiện, da trẻ sơ sinh còn non nớt, nhạy cảm: Lớp bảo vệ (hàng rào da) của trẻ còn non yếu, nên dễ bị xâm nhập bởi vi nấm, vi khuẩn hơn người trưởng thành hoặc trẻ lớn hơn.
- Môi trường ẩm ướt kéo dài: Thay tã chậm, dùng tã không thấm tốt, mặc quần áo quá bó/ không thoáng khí, sống môi trường nóng ẩm (như điều kiện tại Việt Nam)… đều là những yếu tố góp phần khiến da trẻ dễ kích ứng hơn, cũng như dễ bị phá vỡ lớp sừng khiến nấm dễ xâm nhập gây bệnh.
- Tiếp xúc với người bị nhiễm nấm: Khi da bị tổn thương, vi nấm (như Candida) từ môi trường hoặc qua tiếp xúc người – người dễ xâm nhập và phát triển, gây bệnh cho trẻ.
Dấu hiệu nấm da ở trẻ sơ sinh và hăm tã
Da vùng tã của trẻ sơ sinh rất nhạy cảm — chỉ cần ẩm ướt hoặc ma sát nhẹ cũng có thể gây kích ứng. Do đó nhiều mẹ thường hay nhầm lẫn hăm tã và nấm da. Để phân biệt, cha mẹ có thể dựa vào các điểm sau:
| Đặc điểm | Nấm da ở trẻ sơ sinh | Hăm tã |
| Màu da tổn thương | Da đỏ đậm hoặc tím, có thể bóng, nứt, rớm dịch hoặc xuất hiện mụn li ti | Da hồng nhạt đến tím nhẹ, khô, trơn hoặc tróc vảy nhẹ |
| Vị trí xuất hiện | Thường ở nếp gấp da quanh bẹn, đùi, cơ quan sinh dục – nơi ẩm và khó thoáng khí | Xuất hiện chủ yếu trên bề mặt rộng như mông, hông – vùng tiếp xúc trực tiếp với tã/bỉm |
| Hình dạng vết ban | Có thể thành nhiều đốm nhỏ rải rác quanh vùng tã | Thường tập trung thành một vùng với vết đỏ liền mạch |
| Cảm giác & biểu hiện | Bé có thể ngứa, đau rát, quấy khóc khi thay tã | Bé hơi khó chịu nhưng thường giảm nhanh khi thay tã sạch và bôi kem |
| Thời gian hồi phục | Cần bôi thuốc kháng nấm theo chỉ định; có thể mất vài tuần để khỏi hẳn | Chỉ cần bôi kem hăm tã, da thường tự hồi phục sau 1 – 2 ngày |
| Nguyên nhân chính | Do nhiễm vi nấm Candida albicans trong môi trường ẩm | Do ma sát, ẩm ướt, kích ứng nước tiểu/phân |
Khi thấy có các dấu hiệu của nấm da, cha mẹ cần đưa trẻ đến khám bác sĩ, chuyên gia để được thăm khám và chỉ định hướng điều trị cụ thể. Tuyệt đối không nên tự ý mua thuốc tự dùng ở nhà hoặc áp dụng mẹo dân gian chưa được kiểm chứng để tránh tác dụng phụ hay biến chứng cho trẻ.
Phòng ngừa nấm da ở trẻ sơ sinh
Cha mẹ hoàn toàn có thể phòng ngừa nấm da cho bé, bắt đầu từ những thói quen nhỏ mỗi ngày.
Giữ vùng tã luôn khô thoáng
Sau mỗi lần bé đi tiểu hoặc đi ngoài, cha mẹ nên thay tã ngay để tránh ẩm ướt kéo dài – nguyên nhân chính khiến nấm Candida phát triển mạnh. Nên rửa sạch vùng mông – bẹn bằng nước ấm hoặc khăn ướt không hương liệu, lau thật khô rồi để da “thở” vài phút trước khi mặc tã mới.
Chọn tã và quần áo phù hợp
Cha mẹ cần chọn tã/bỉm có khả năng thấm hút tốt, mềm mại và thoáng khí. Không nên dùng tã quá chật vì sẽ gây ma sát và bí hơi, khiến da bé dễ kích ứng.
Ngoài ra, quần áo của bé nên làm từ vải cotton hoặc chất liệu tự nhiên, giúp da “thở” dễ dàng hơn và hạn chế tích tụ mồ hôi để tránh môi trường lý tưởng cho nấm phát triển.
Giặt và vệ sinh đồ dùng của bé đúng cách
Quần áo, khăn, chăn gối của trẻ cần được giặt riêng bằng nước giặt chuyên dụng cho trẻ sơ sinh, không chứa hương liệu hoặc chất tẩy mạnh.
Sau khi giặt, nên phơi dưới ánh nắng mặt trời để diệt khuẩn tự nhiên. Cùng với đó, các vật dụng tiếp xúc thường xuyên như nôi, chiếu, gối cũng cần được khử khuẩn định kỳ để ngăn ngừa vi nấm tái phát.
Giữ môi trường sống khô ráo, mát mẻ
Nhiệt độ phòng lý tưởng cho trẻ sơ sinh là khoảng 24 – 26°C, độ ẩm khoảng 50 – 60%. Vào mùa nồm hoặc thời tiết ẩm, cha mẹ có thể dùng máy hút ẩm hoặc bật quạt thông gió để không khí lưu thông. Tránh để bé nằm lâu trong môi trường nóng bí hoặc ra nhiều mồ hôi – vì đây là điều kiện lý tưởng để nấm da sinh sôi.
Dưỡng da và bảo vệ hàng rào tự nhiên
Việc thoa kem dưỡng ẩm dịu nhẹ, không hương liệu giúp củng cố hàng rào da, hạn chế vi nấm xâm nhập. Đặc biệt, với vùng mặc tã/bỉm, cha mẹ nên sử dụng kem chống hăm chứa kẽm oxit (zinc oxide) để tạo lớp màng bảo vệ.
Tuyệt đối không bôi phấn rôm, dầu hay thuốc kháng nấm khi chưa có hướng dẫn từ bác sĩ, vì có thể khiến tình trạng nặng hơn.
Theo dõi và phát hiện sớm dấu hiệu bất thường
Nếu sau 2 – 3 ngày giữ khô và chăm sóc đúng mà vùng đỏ không giảm, hoặc thấy mụn nước, rớm dịch, lan vào nếp gấp da – cần đưa bé đi khám Da liễu/Nhi khoa để xác định nguyên nhân và điều trị đúng cách.
Hy vọng với những chia sẻ trên đây đã giúp bạn hiểu được nấm da ở trẻ sơ sinh là tình trạng thường gặp nhưng hoàn toàn có thể phát hiện sớm và chủ động phòng ngừa nếu cha mẹ nắm được dấu hiệu nhận biết sớm cũng như chăm sóc đúng cách. Hãy luôn giữ vùng tã của bé sạch – khô – thoáng, lựa chọn sản phẩm chăm sóc dịu nhẹ, và đưa bé đi khám khi có dấu hiệu bất thường. Bởi một làn da khỏe là nền tảng cho một em bé khỏe mạnh – và điều đó bắt đầu từ sự quan tâm mỗi ngày của cha mẹ.